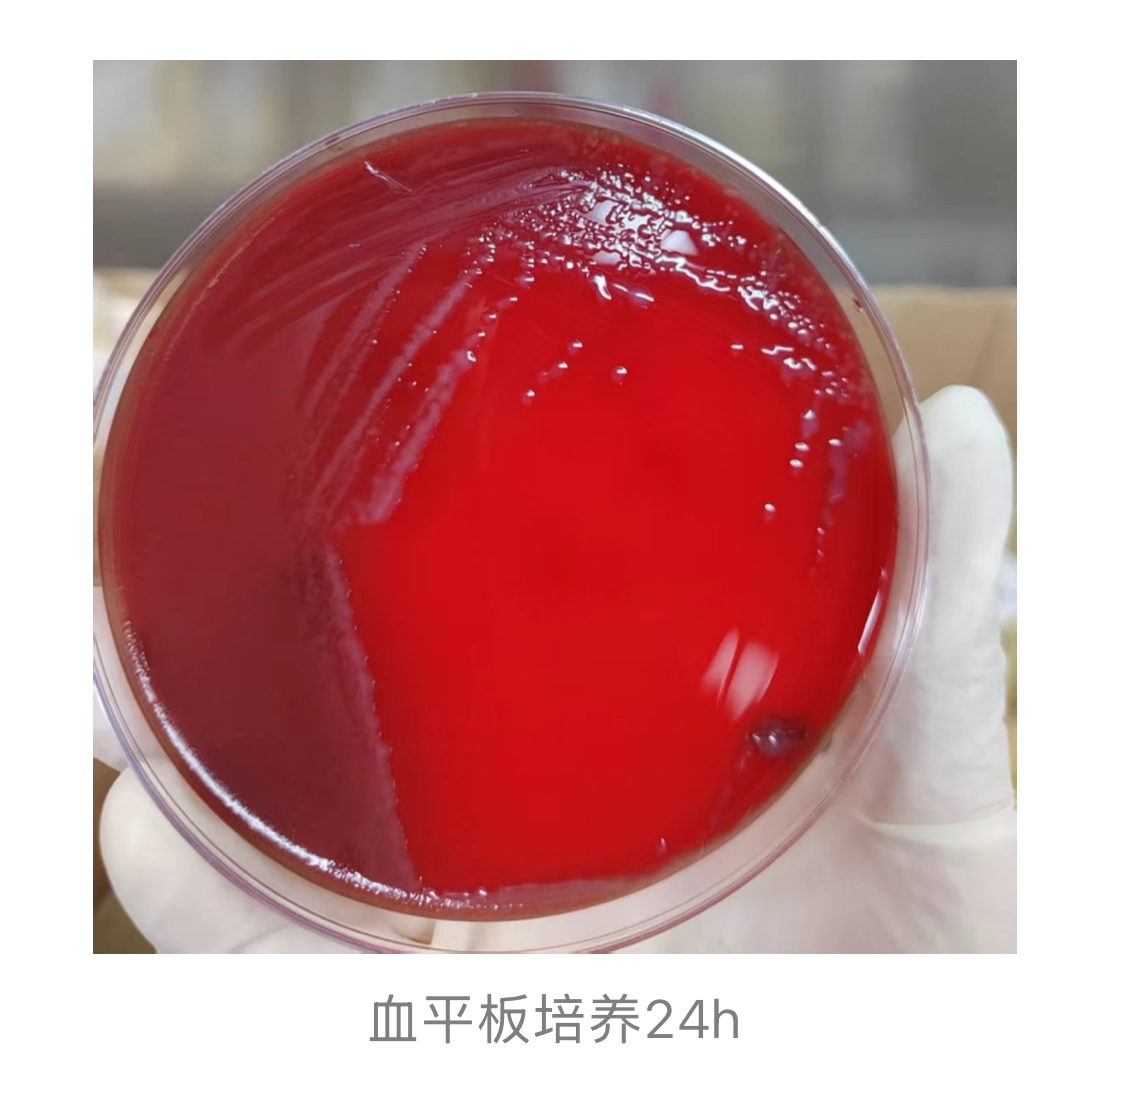
1775032197662318.jpg 1775032197662318.jpg

从发热到进ICU,脑膜炎奈瑟菌“突袭”22岁青壮年
作者:张莉
,东莞东华医院
脑膜炎奈瑟菌
(Neisseria meningitidis, Nm)也称为脑膜炎球菌,是流行性脑脊髓膜炎
(流脑)的主要致病菌。Nm通过人与人之间的接触,经由气溶胶和口腔或鼻腔分泌物传播,可导致急性细菌性脑膜炎
。最易感染人群为1岁以下的婴儿、青少年和年轻成年人,其他可能感染Nm的人群包括那些存在补体系统缺陷和无脾脏的人[1]。
即使在具备疫苗预防与抗生素治疗的背景下,流脑的病死率仍维持在10%-20%。幸存者中有10%-20%会发展出长期后遗症,包括听力损失、肢体缺失、皮肤疤痕、神经发育障碍,以及高达36%的人会出现身心功能方面的缺陷[1]。
据荚膜多糖的结构及免疫原性差异,Nm可分为12个血清群与若干不可分类群,其中A、B、C、X、W及Y血清群引发了全球绝大多数侵袭性脑膜炎球菌病[2-3]。Nm的传播能力在很大程度上可归因于其无症状定殖的特性。研究表明,约10%的健康人群鼻咽部黏膜可携带该菌而不出现临床症状,这些无症状携带者是疾病传播的关键源头[4]。
Nm侵入血液循环后可引发严重侵袭性感染,典型临床表现为突发高热、皮肤和粘膜的瘀斑或瘀点、低血压及多器官功能障碍。病情进展急骤,若未能及时获得有效治疗,常迅速发展为感染性休克
,乃至死亡[5]。
本文报道一例青年患者因脑膜炎奈瑟菌引起血流和中枢系统感染的病例,旨在系统分析该少见病原菌的实验室检测方法与临床特征,总结其诊断与治疗要点,以期为未来类似感染的临床管理及医院感染防控实践提供依据。
案例经过
患者男,22岁,因“发热
、腹泻
、呕吐
1天”于2025年12月14日入院。
现病史
患者就诊一天前早晨无诱因出现畏寒、寒战,后出现发热,最高体温40.0℃,伴腹泻,解黄色水样便10余次,无里急后重,有恶心、呕吐,呕吐1次,均为胃内容物,伴出冷汗,无腹痛、腹胀、肢体抽搐等不适。曾在当地医院就诊,予退热、抗病毒等治疗后症状无改善。就诊当日,患者出现头痛
,伴少尿,腹泻、呕吐无好转,为求进一步诊治来我院门诊就诊,门诊拟“发热”收治我院感染科。
起病来,患者精神、胃纳、睡眠差,大便如上述,小便量少,近期体重无明显变化。入院后予头孢他啶
抗感染及补液等治疗,患者病情逐渐加重,有一过性凝视,与患者家属沟通后转ICU进一步诊疗。
实验室检查
12月14日送检双侧双套血培养
,12月15日需氧瓶报阳,直接涂片
革兰染色:革兰阴性、呈肾形的双球菌。接种血平板,35℃、5% CO2环境孵育24h,血琼脂平板上可见圆形、灰色、隆起、表面光滑、呈半透明状的露滴样菌落,直径约1-5mm,未见色素生成及溶血现象。结合菌落和镜下细菌形态特点,疑似脑膜炎奈瑟菌。
经家属同意,从报阳血培养瓶抽取200毫升液体,使用FilmArray检测平台检测,约1小时后测出脑膜炎奈瑟球菌。
将纯菌用VITEK2 NH卡做鉴定,同时做质谱鉴定,使用含5%羊血的MH琼脂进行药敏试验
。最终,VITEK2和质谱鉴定均为脑膜炎奈瑟菌,药敏结果为头孢曲松
中介、环丙沙星
耐药,美罗培南
、米诺环素
、复方新诺明和氯霉素
均为敏感,β内酰胺酶为阴性。此外,脑脊液NGS结果提示脑膜炎奈瑟菌。

案例分析
人类是脑膜炎奈瑟菌唯一的自然宿主和易感者。在多数情况下,感染后仅表现为无症状带菌状态或隐性感染,病原体可在鼻咽部短暂定殖后即被宿主免疫系统清除。流行性脑脊髓膜炎的潜伏期通常为1至7天,以2至3天最为常见。其临床表现可分为普通型、暴发型及轻型。其中,普通型病程具有阶段性特征,依次表现为前驱期、败血症
期、脑膜脑炎
期和恢复期;而暴发型则起病急骤、病情危重,若不及时救治,常于24小时内死亡[6]。
患者家属诉其夜间点外卖吃宵夜,一人用餐,次日晨出现高热,达40.0℃,随后出现呕吐及腹泻的症状。结合病史,不排除患者呕吐腹泻导致免疫力下降,使得暂定殖于鼻咽部的脑膜炎奈瑟菌入血,之后突破血脑屏障引起中枢神经系统感染。患者血液培养出脑膜炎奈瑟菌,且脑脊液NGS结果提示脑膜炎奈瑟菌,均表明目前菌血症及细菌性颅内感染明确。患者高热、意识不清,间断躁动明显,但患者脑膜炎刺激征(-),且无剧烈头痛、喷射状呕吐的症状,综合考虑比较符合流脑普通型中的败血症期和脑膜脑炎期。
据《中华预防医学杂志》发表的《2005-2019年中国538株脑膜炎奈瑟菌抗生素耐药性分析》,中国2005-2019年538株脑膜炎奈瑟菌对阿奇霉素
、美罗培南、氯霉素、利福平
、头孢曲松等5种抗生素均敏感,不再推荐环丙沙星和磺胺甲基异噁唑作为临床救治和预防性服药首选药物[7]。笔者实验室出具的药敏报告显示头孢曲松中介,与该文章的耐药性分析结果不太一致,可能由地区用药差异性引起该类抗生素的不敏感性。临床医生用美罗培南替代头孢曲松抗脑膜炎奈瑟菌感染后,疗效较佳,患者的PCT和CRP值逐步下降,脑脊液性状由最初的淡黄浑浊、有絮状物变成清亮透明,脑脊液中的蛋白质量逐步降低。
本案例值得关注的是在血培养瓶报阳一小时后,利用FilmArray检测平台检测出致病菌,上报给临床和院感部,极大提升了诊治效率和防控措施。流脑属于乙类传染病,鉴定结果上报临床的同时,也报告了院感科,对患者进行单间隔离治疗,对患者家属进行相关的健康宣教。医务人员诊疗时严格执行手卫生,陪护人员佩戴口罩,同时按照规定做好感染防控,接触人员根据药敏建议按个人需要使用复方磺胺甲噁唑
防治感染。
总结
本案例分析表明,脑膜炎奈瑟菌感染具有起病急骤、进展迅速、病死率与致残率高等特点,早期明确诊断与针对性治疗是改善预后的关键。检验人员在实验室检测中,除需熟练掌握病原体形态学特征外,亦应及时与临床医师沟通,为诊疗决策提供支持。同时,应综合运用PCR、NGS及荚膜多糖抗原检测等多种技术手段,以期为临床提供快速、准确的病原学诊断依据。
脑膜炎奈瑟菌的传播与流行是病原体生物学特征与宿主社会行为因素相互作用的结果。将学校、集体宿舍等聚集场所纳入常态化主动监测体系,并构建覆盖多传播途径、针对多风险人群的立体化综合防控网络,是有效控制其扩散的关键策略[4]。
预防脑膜炎奈瑟菌感染的核心策略包括实施主动免疫,例如接种A群C群脑膜炎球菌多糖疫苗
等针对性疫苗。与此同时,保持良好的个人卫生习惯、避免与已知感染者密切接触,以及在流行季节或感染发生期间尽量减少前往人群密集、通风不良的公共场所,均为降低感染风险的有效非药物干预措施。
参考文献略。
来源:检验医学网